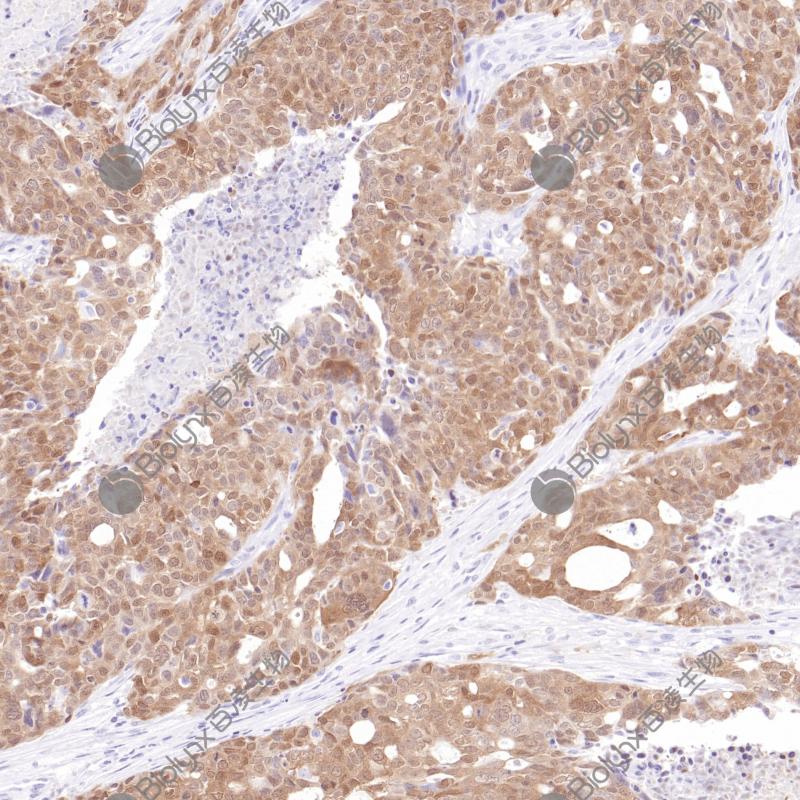
子宫内膜癌p16（BPM6238）染色

产品中心

宫颈上皮内瘤变p16(BPM6238)染色
子宫内膜癌p16(BPM6238)染色
p16 鼠单克隆抗体
p16 INK4A(p16)是一种细胞周期蛋白依赖性激酶(CDKs)抑制剂,参与细胞周期的调控。当P16 INK4A基因发生缺失、突变等,不能抑制CDK4,最终导致细胞进入恶性增殖,加速肿瘤发生。p16 INK4A主要响应致癌基因表达、染色质断裂和各种压力胁迫等事件,这有利于受损细胞几乎无一例外地被衰老程序所捕获。因此,p16 INK4A的表达是常用的衰老细胞标志物。另外,p16 INK4A蛋白的高表达可作为宫颈癌细胞中的预测性生物标志物。
Specifications
- 目录号
- BX50261
- 克隆号
- BPM6238
- 阳性对照
- 宫颈上皮内瘤变
- 亚细胞定位
- 细胞核
- 组织类型
- FFPE
- 修复方式
- HIER
- 稀释比
- 1:100-1:200
- 规格
- 100μl/vial, 1ml/vial
- 用途
- RUO


